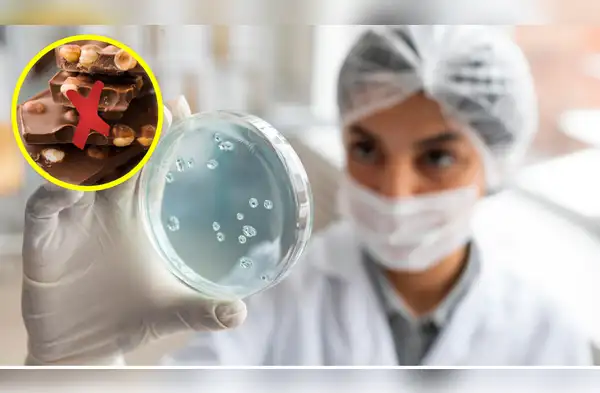
wapa.pe

El producto que incluso podría haber llegado a otros países, incluido el Perú, a través de distintos canales de venta, estaría contaminado con salmonela.
Únete al canal de Whatsapp de Wapa
Las autoridades sanitarias de Estados Unidos emitieron una alerta tras detectar la posible presencia de salmonela en una marca de chocolates, lo que motivó su retiro inmediato del mercado. El aviso busca prevenir riesgos a la salud de los consumidores y advertir sobre un producto que incluso podría haber llegado a otros países, incluido el Perú, a través de distintos canales de venta.
El producto involucrado es la barra de chocolate de la marca Spring & Mulbery, específicamente el sabor "Mint Leaf Date Sweetened Chocolate Bar", el cual fue retirado luego de identificarse un riesgo sanitario. De acuerdo con especialistas, el consumo de este chocolate podría provocar síntomas como fiebre, diarrea y dolor abdominal, afecciones asociadas a infecciones por salmonela.
Debido a que el producto se comercializaba de manera virtual, existe la posibilidad de que haya sido adquirido fuera del país de origen y enviado a consumidores en el extranjero. Además, muchas marcas estadounidenses cuentan con distribución internacional, por lo que se recomienda extremar precauciones y evitar su consumo.
Las autoridades de la Administración de Alimentos y Medicamentos (FDA) confirmaron que el producto presentaba contaminación bacteriana, lo que podría derivar en cuadros de deshidratación severa y, en algunos casos, hospitalización. El riesgo es mayor en niños y personas con sistemas inmunológicos más vulnerables, debido al alto consumo de este tipo de dulces en ese grupo.
Según el comunicado oficial, la alerta sanitaria corresponde específicamente al lote "#025255". Este chocolate estuvo disponible tanto en supermercados como en plataformas de venta online, lo que amplió su alcance a distintos mercados. La distribución del producto comenzó el 15 de setiembre de 2025 en Estados Unidos, con posibilidad de envío a otros países.
NO DEJES DE LEER: ES OFICIAL | GRAN REMATE en la Embajada de EE.UU. en Lima: Mira cómo conseguir computadoras, muebles, electrodomésticos y más
Tras la advertencia, se solicitó a los puntos de venta suspender la comercialización del producto y retirar las unidades disponibles. Hasta nuevo aviso, el chocolate Spring & Mulbery en su versión "Mint Leaf Date Sweetened Chocolate Bar" permanecerá fuera del mercado mientras se verifican y refuerzan las condiciones sanitarias correspondientes.